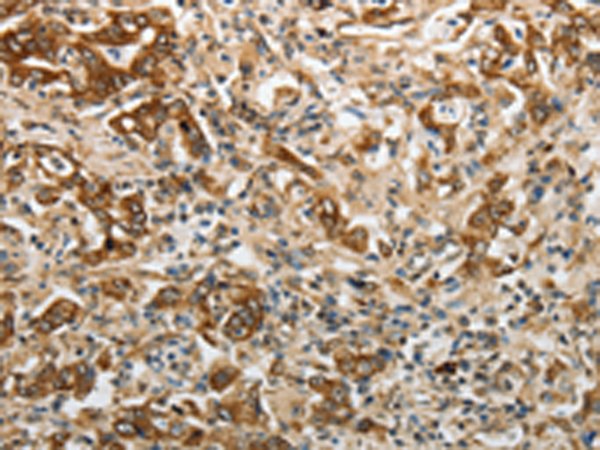

别名:YB1; BP-8; CSDB; DBPB; YB-1; CSDA2; NSEP1; NSEP-1; MDR-NF1应用:IHC
反应种属:Human, Mouse, Rat
规格:50μl/100μl
| Description |
|---|
| This protein mediates pre-mRNA alternative splicing regulation. It binds to splice sites in pre-mRNA and regulates splice site selection and contributes to the regulation of translation by modulating the interaction between the mRNA and eukaryotic initiation factors. It can regulates the transcription of numerous genes. Its transcriptional activity on the multidrug resistance gene MDR1 is enhanced in presence of the APEX1 acetylated form at ‘Lys-6’ and ‘Lys-7’. Binds to promoters that contain a Y-box (5′-CTGATTGGCCAA-3′), such as MDR1 and HLA class II genes. Promotes separation of DNA strands that contain mismatches or are modified by cisplatin. Has endonucleolytic activity and can introduce nicks or breaks into double-stranded DNA (in vitro). |
| Specification | |
|---|---|
| Aliases | YB1; BP-8; CSDB; DBPB; YB-1; CSDA2; NSEP1; NSEP-1; MDR-NF1 |
| Swissprot | P67809 |
| Host/Isotype | Rabbit IgG |
| Storage | Store at 4°C short term. Aliquot and store at -20°C long term. Avoid freeze/thaw cycles. |
| Species Reactivity | Human, Mouse, Rat |
| Immunogen | Synthetic peptide of human YBX1 |
| Formulation | pH7.4 PBS, 0.05% NaN3, 40% Glycerol |
| Application | |
|---|---|
| IHC | 1/25-1/100 |
| ELISA | 1/2000-1/5000 |
![]() |
The image is immunohistochemistry of paraffin-embedded Human brain tissue using P11151(YBX1 Antibody) at dilution 1/15. (Original magnification: ×200) |
![]() |
The image is immunohistochemistry of paraffin-embedded Human gastric cancer tissue using P11151(YBX1 Antibody) at dilution 1/15. (Original magnification: ×200) |
本公司的所有产品仅用于科学研究或者工业应用等非医疗目的,不可用于人类或动物的临床诊断或治疗,非药用,非食用。
暂无评论
本公司的所有产品仅用于科学研究或者工业应用等非医疗目的,不可用于人类或动物的临床诊断或治疗,非药用,非食用。
中文

发表回复